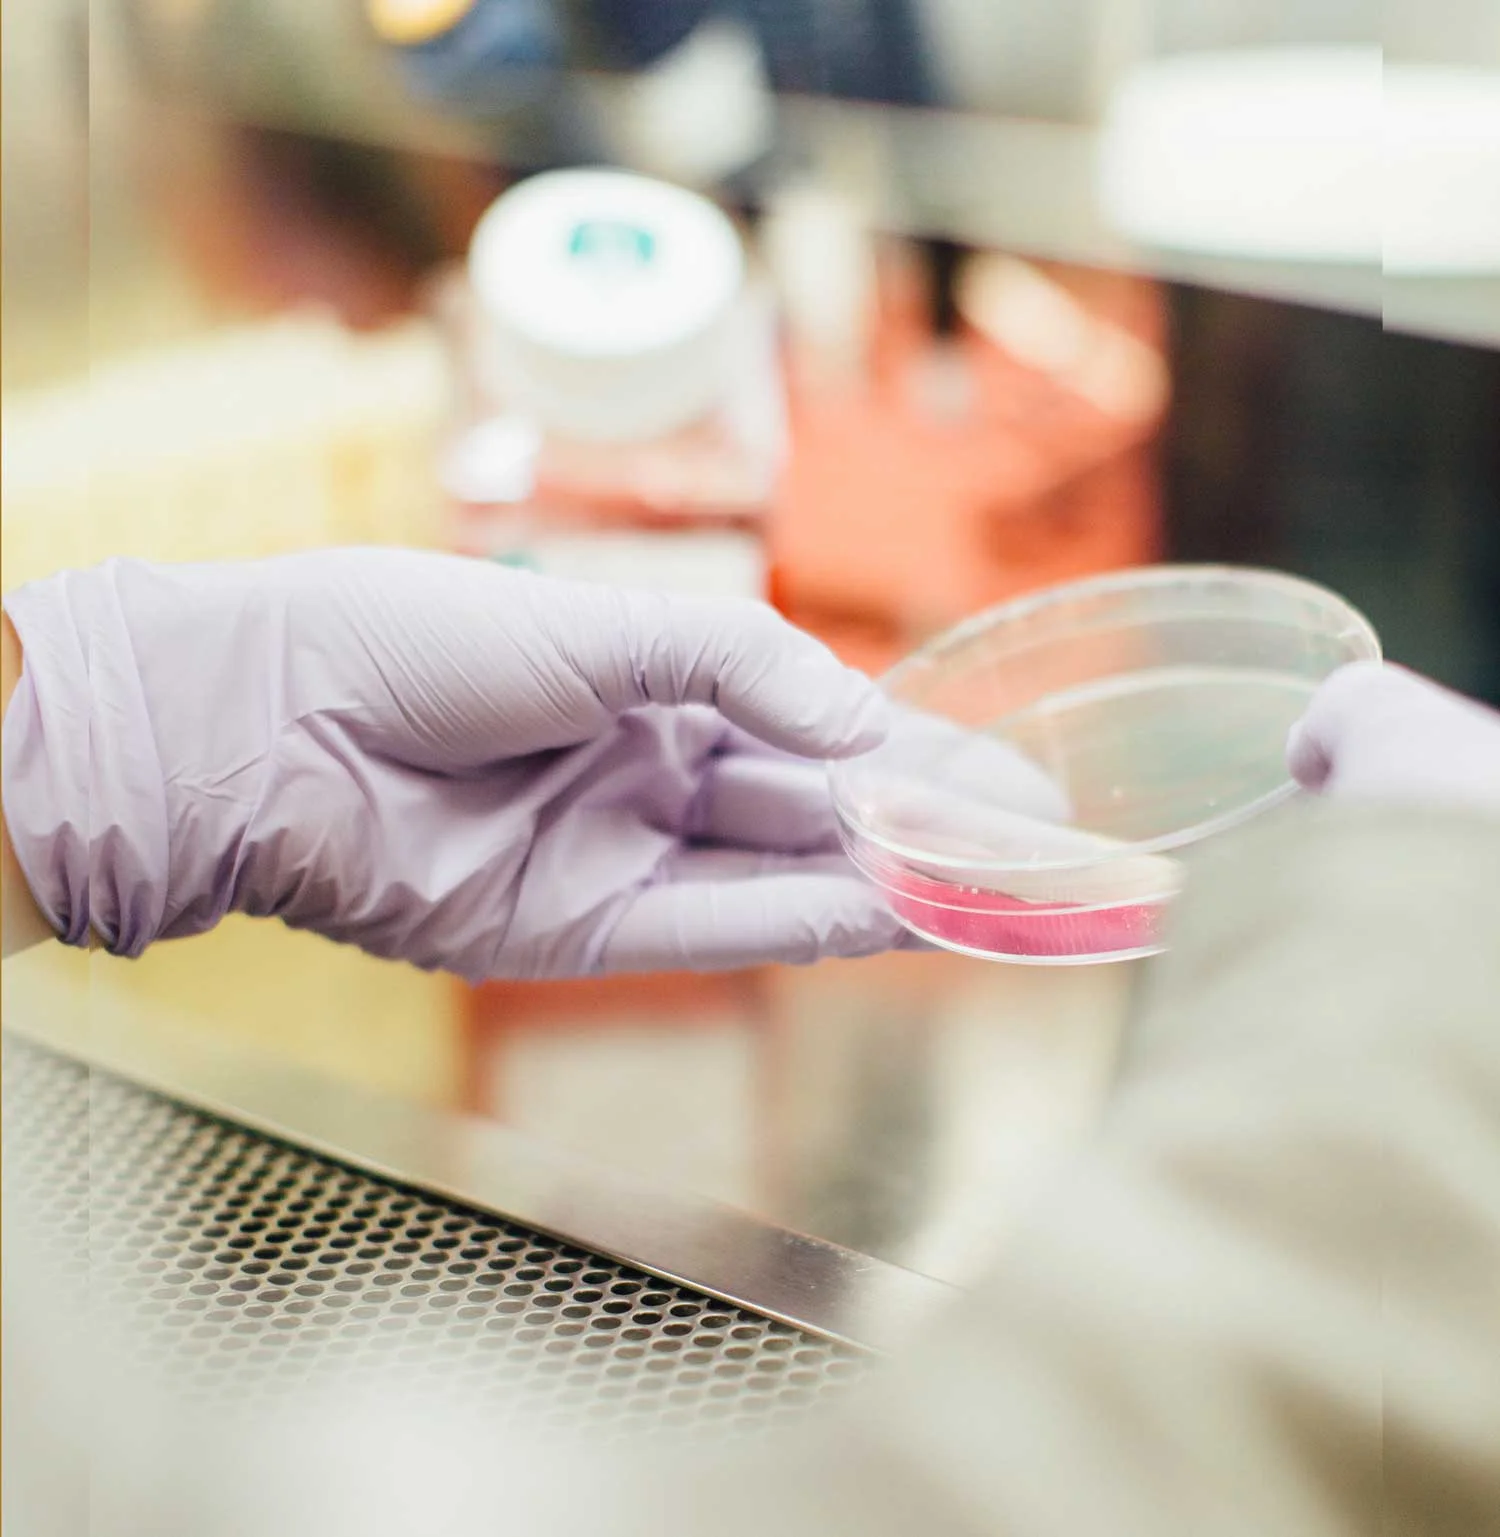

Vision: Improve health for all in rural, regional and Aboriginal communities.
Background
Rural Workforce Agency Victoria (RWAV) is a non-profit government funded organization which works to improve access and sustainability of healthcare services by developing and delivering health workforce solutions in rural, regional and Aboriginal communities in Victoria.
It specializes in recruitment, workforce support, retention and facilitating outreach services. RWAV’s mission is to develop and deliver solutions to enhance rural, regional and Aboriginal communities’ access to the health workforce.
RWAV delivers services throughout rural and regional Victoria – a network of approximately 2.3 million people, covering 425 Primary Care Centres including 356 GP practices, 47 Community Health Centres and 22 Aboriginal Health Services.
Through recruitment and retention, practice capacity and capability and informed workforce planning RWAV is ensuring the rural health workforce has access to comprehensive occupational support.
Challenge
RWAV approached Conscious Governance to complete an External Board and Governance Review. This included a desktop review of Board documents, an on-site desk audit of governance processes, electronic stakeholder survey, one-on-one interviews with Board members and the eventual collation and analysis of evaluation results.
RWAV wanted to evaluate its governance practices and realign the Board to meet the challenges of the future.
Impact
A direct outcome of the evaluation was an increased focus on strategy and extracting strategic implications from reporting mechanisms. The evaluation also demonstrated ways to improve the processes, the decision making, and the outputs of the Board and senior executive team.
Another outcome was a restructuring of RWAV’s constitution, ensuring it remains relevant and fit-for-purpose in a modern organization.
We ended the evaluation with a series of 26 recommendations each aimed at fine tuning the strategic discussion in the Boardroom to support RWAV’s important work.